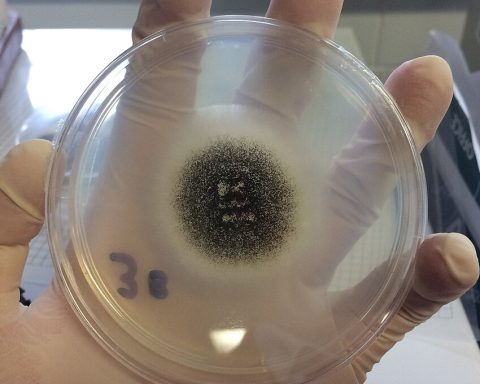

Τα μέτρα για την εξάλειψη και την αποφυγή διάδοσης του μεταχρωματικού έλκους πλατάνου, μιας ασθένειας που εδώ και δύο δεκαετίες εξαπλώνεται στα πλατανοδάση της Δυτικής Ελλάδας απο τον παθογόνο μύκητα Ceratocystis platani, περιλαμβάνονται στην ΚΥΑ που υπέγραψαν ο Υπουργός Αγροτικής Ανάπτυξης και Τροφίμων, Γιώργος Γεωργαντάς, ο Αναπληρωτής Υπουργός Οικονομικών, Θόδωρος Σκυλακάκης, και ο Υφυπουργός Περιβάλλοντος και Ενέργειας, Γιώργος Αμυράς.
Τα μέτρα που θεσπίζονται, προβλέπονται σε κανονισμούς της Ευρωπαϊκής Επιτροπής, σε σχετική μελέτη του «ΕΛΓΟ Δήμητρα» και στις εισηγήσεις των Δασικών Υπηρεσιών.
Σύμφωνα με την ΚΥΑ:
- Συνεχίζονται οι μακροσκοπικοί φυτοϋγειονομικοί έλεγχοι σε όλη τη χώρα, οι οποίοι υλοποιούνται από το Μπενάκειο Φυτοπαθολογικό Ινστιτούτο σύμφωνα με το πρόγραμμα ετήσιων επισκοπήσεων, που συντάσσεται με συνεργασία υπηρεσιών του ΥΠΕΝ και ΥΠΑΑΤ.
- Η Δ/νση Προστασίας Δασών της Γενικής Δ/νσης Δασών και Δασικού Περιβάλλοντος ΥΠΕΝ ορίζεται υπεύθυνη για τη σύνταξη εθνικού σχεδίου δράσης.
- Μετά από την επιβεβαίωση κρούσματος οι οριοθετημένες ζώνες γύρω από αυτό αποτυπώνονται σε ψηφιακούς χάρτες, που θα αναρτώνται σε ειδικό διαδικτυακό τόπο.
- Σχεδιάζονται Τοπικά Σχέδια Δράσης, όπου ορίζονται τα μέτρα αντιμετώπισης και ο ρόλος κάθε εμπλεκόμενης αρμόδιας υπηρεσίας ή φορέα.
- Στις οριοθετημένες ζώνες εφαρμόζονται εντατικές επισκοπήσεις. Αν μετά την επισκόπηση δεν διαπιστωθεί -στη διάρκεια 10 συνεχών ετών αντί για 2 έτη που ίσχυε στην παλαιότερη ΚΥΑ- η παρουσία του επιβλαβούς οργανισμού, τότε οι ζώνες παύουν να ισχύουν, όπως και τα μέτρα αποτροπής της διάδοσης της ασθένειας.
- Στα ενδεδειγμένα μέτρα που αφορούν στην κοπή, την καταστροφή με καύση ή υγειονομική ταφή των προσβεβλημένων δέντρων, πλέον αναφέρεται και η δυνατότητα μεταφοράς και περαιτέρω διαχείρισης της προσβεβλημένης ξυλείας με θερμική επεξεργασία σε κατάλληλες μονάδες (π.χ. παραγωγή βιομάζας) πάντα υπό την εποπτεία της οικείας Δασικής Υπηρεσίας.
- Ορίζονται συγκεκριμένα διοικητικά πρόστιμα έως και 50.000 ευρώ για τους παραβάτες, π.χ. μη απολύμανση των εργαλείων κοπής, διακίνηση φυτών ή ξυλείας πλατάνου προερχόμενα από προσβεβλημένη περιοχή, παρακώλυση ελέγχων. Τα Διοικητικά Πρόστιμα αποτελούν πόρο για τον λογαριασμό του Ειδικού Φορέα Δασών που διαχειρίζεται το Πράσινο Ταμείο, ώστε να χρησιμοποιηθούν για την άμεση αποκατάσταση δασικών οικοσυστημάτων.
Ο Υπουργός Αγροτικής Ανάπτυξης και Τροφίμων, Γιώργος Γεωργαντάς, δήλωσε: «Από την πρώτη στιγμή που ενημερωθήκαμε για την ασθένεια του μεταχρωματικού έλκους στα πλατάνια της Ελλάδας λάβαμε τα δέοντα μέτρα για να τα προστατεύσουμε. Με την συγκεκριμένη ΚΥΑ, αφού λάβαμε υπόψιν τις εισηγήσεις των Δασικών Υπηρεσιών και την μελέτη του «ΕΛΓΟ Δήμητρα» και με την αρωγή της τεχνολογίας θα κάνουμε ό,τι περνάει από το χέρι μας για να αντιμετωπιστεί αυτό το πρόβλημα και να μην πληγεί ο δασικός μας πλούτος.».
Ο Υφυπουργός Περιβάλλοντος και Ενέργειας, Γιώργος Αμυράς, δήλωσε: «Το μεταχρωματικό έλκος είναι μια ύπουλη ασθένεια που απειλεί παραποτάμια οικοσυστήματα και βιοτόπους της χώρας. Με τη συνεργασία που έχουμε αναπτύξει στο Υπουργείο Περιβάλλοντος με τον Υπουργό Αγροτικής Ανάπτυξης και Τροφίμων, Γιώργο Γεωργαντά, θεσπίζουμε ένα αυστηρό πλαίσιο για τους ελέγχους, την καταγραφή και την αντιμετώπιση της ασθένειας των πλατάνων».